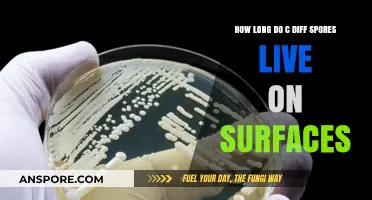
C. Diff Spores Survival: How Long Do They Live on Surfaces?

Milky Spore is a popular, environmentally friendly solution used to control Japanese beetle grubs in lawns and gardens. If you're looking to purchase Milky Spore, there are several reliable options available. Many local garden centers, nurseries, and hardware stores carry it, especially during the spring and summer months when grub control is most critical. Additionally, online retailers like Amazon, Home Depot, and Lowe’s offer Milky Spore for convenient delivery to your doorstep. Specialty gardening websites and pest control suppliers are also great sources, often providing bulk options or bundled kits for larger areas. Always ensure you’re buying from a reputable seller to guarantee the product’s effectiveness and authenticity.
| Characteristics | Values |
|---|---|
| Product Name | Milky Spore (Bacillus popilliae) |
| Purpose | Biological control of Japanese beetle grubs in lawns |
| Application Method | Granular application to soil |
| Coverage Area | Varies by product; typically 2,500 to 7,000 sq. ft. per 10 oz |
| Application Timing | Best applied in late summer or early fall when grubs are actively feeding |
| Effectiveness Duration | Up to 20 years once established in the soil |
| Environmental Impact | Eco-friendly, safe for pets, humans, and beneficial insects |
| Availability | Online retailers (Amazon, Home Depot, Lowe's, DoMyOwn), garden centers, and specialty pest control stores |
| Price Range | $20 to $60 depending on quantity and brand |
| Brand Examples | Bonide, St. Gabriel Organics, Ferti-Lome |
| Packaging Sizes | Commonly available in 10 oz, 20 oz, and larger bulk sizes |
| Application Tools | Spreader or manual application |
| Storage | Store in a cool, dry place away from direct sunlight |
| Shelf Life | Typically 2-3 years if stored properly |
| Certification | OMRI Listed for organic use |
| Customer Reviews | Generally positive, with effectiveness noted over time |
Explore related products
What You'll Learn

Local Garden Centers
Beyond purchasing, local garden centers serve as valuable resources for troubleshooting. Staff can guide you on identifying grub damage, such as brown patches or spongy turf, and explain how milky spore works: it’s a bacterium that infects and kills grubs over time, building up in the soil for long-term control. They might also recommend complementary practices, like aerating your lawn to improve spore penetration or overseeding to repair damaged areas. This hands-on advice is particularly useful for first-time users who want to ensure they’re applying the product correctly.
One advantage of buying from a local garden center is the ability to inspect the product before purchase. Check the packaging for expiration dates, as milky spore loses potency over time, and ensure the granules are dry and free of clumps. Some centers may even allow you to purchase small quantities for trial, especially if you’re treating a limited area. This flexibility is less common with online retailers, where you’re often limited to pre-set package sizes.
However, availability can vary by location and season, so call ahead to confirm stock. Smaller garden centers may carry milky spore only during peak grub control seasons, while larger chains like Lowe’s or Home Depot are more likely to have it year-round. If your local center is out of stock, they might offer to order it for you or suggest alternative organic solutions like beneficial nematodes. This personalized service is a key benefit of shopping locally, especially for gardeners who prefer face-to-face interactions over online browsing.
Finally, supporting local garden centers when buying milky spore contributes to your community’s economy and fosters a network of knowledgeable gardeners. Many centers host workshops or seminars on lawn care, providing opportunities to learn more about grub control and other gardening topics. By purchasing locally, you’re not just buying a product—you’re investing in a resource that can help you maintain a healthy, grub-free lawn for years to come.
Does Spore Effectively Work on Grass-Type Pokémon? A Detailed Analysis
You may want to see also

Online Retailers (Amazon, eBay)
Online retailers like Amazon and eBay have become go-to destinations for purchasing milky spore, a natural lawn treatment that targets Japanese beetle grubs. These platforms offer convenience, variety, and competitive pricing, making them ideal for homeowners seeking eco-friendly pest control solutions. Amazon, in particular, features numerous listings from both established brands and third-party sellers, often with detailed product descriptions and customer reviews to guide your decision. eBay, while less structured, provides access to bulk quantities and vintage or hard-to-find formulations, appealing to those with specific needs or larger lawn areas.
When shopping on Amazon, look for products with clear application instructions and verified customer feedback. Milky spore is typically sold in granular form, with recommended dosages ranging from 1 to 2 teaspoons per square yard. Many listings include application tools or spreaders, which can simplify the process for first-time users. Be cautious of overly cheap options, as they may lack potency or proper storage conditions, which are critical for the spores’ viability. Amazon’s subscription and save options can also be a practical choice for long-term lawn maintenance.
EBay’s platform requires a more discerning approach due to its auction-based nature and varying seller reliability. Focus on sellers with high ratings and detailed product histories, especially those offering unopened, properly stored milky spore. Bulk purchases are common here, often at lower prices per unit, but ensure the product’s expiration date is well into the future. Some sellers may include application tips or seasonal discounts, making eBay a valuable resource for experienced users or those treating extensive landscapes.
One key advantage of both platforms is the ability to compare products side by side. Amazon’s algorithm often suggests complementary items, such as lawn aerators or organic fertilizers, which can enhance the effectiveness of milky spore. eBay’s search filters allow you to narrow results by price, location, or condition, helping you find the best deal. However, always verify the seller’s return policy and shipping times, as these can vary significantly and impact your treatment schedule.
In conclusion, Amazon and eBay offer distinct advantages for purchasing milky spore, catering to different preferences and needs. Amazon excels in user-friendly shopping and reliable product information, while eBay shines for bulk buyers and those seeking unique formulations. By leveraging the strengths of each platform and exercising caution, you can secure a high-quality product that effectively combats Japanese beetle grubs while maintaining a healthy lawn.
Effective Temperatures to Eliminate Mold Spores: A Comprehensive Guide
You may want to see also

Home Improvement Stores (Lowes, Home Depot)
Home improvement giants like Lowe's and The Home Depot have become go-to destinations for homeowners tackling everything from minor repairs to major renovations. Among their extensive inventory, you’ll find milky spore, a natural, eco-friendly solution for controlling Japanese beetle grubs in lawns. These stores cater to both seasoned gardeners and DIY enthusiasts, offering milky spore in various forms, including granular applications and ready-to-use kits. Whether you’re shopping in-store or online, their product descriptions often include application instructions, coverage areas, and seasonal tips, making it easier to choose the right option for your lawn size and grub infestation level.
When visiting Lowe's or Home Depot, you’ll typically find milky spore in the lawn and garden care section, often near other organic pest control products. Lowe's, for instance, carries brands like *St. Gabriel Organics*, which offers a 20-pound bag designed to treat up to 7,000 square feet. Home Depot stocks *BioLogic* milky spore, available in 10-pound bags suitable for 2,500 square feet. Both stores emphasize the product’s long-term effectiveness—up to 20 years—and its safety for pets, children, and beneficial insects. Look for seasonal promotions or bundle deals, especially during spring and fall, when grub control is most critical.
For those new to milky spore, the application process is straightforward but requires patience. Both Lowe's and Home Depot provide detailed instructions, often printed on the packaging or available online. Generally, you’ll need to apply the granules evenly across your lawn using a spreader, then water thoroughly to activate the spores. The best time to apply is late summer or early fall, when grubs are actively feeding. Repeat applications may be necessary for severe infestations, but the stores’ staff can guide you on dosage and timing based on your lawn’s condition.
One advantage of purchasing milky spore from these home improvement stores is the convenience of pairing it with other lawn care essentials. For example, you can pick up a broadcast spreader, soil test kit, or organic fertilizer in the same trip. Both Lowe's and Home Depot also offer online resources, such as how-to videos and expert advice, to ensure you get the most out of your purchase. Their return policies provide added peace of mind, allowing you to exchange or return the product if it doesn’t meet your expectations.
While milky spore is a popular choice, it’s worth noting that Lowe's and Home Depot also carry alternative grub control solutions, including nematodes and chemical treatments. However, milky spore stands out for its sustainability and minimal environmental impact. By choosing this option, you’re not only addressing a current grub problem but also investing in the long-term health of your lawn. Whether you’re a first-time user or a seasoned gardener, these home improvement stores make it easy to find, purchase, and apply milky spore effectively.
Extending Mushroom Spores Lifespan: Fridge Storage Tips and Duration
You may want to see also
Explore related products

Specialty Pest Control Shops
One standout advantage of specialty shops is their focus on eco-friendly and long-term solutions. Milky Spore, for example, is a bacterium that multiplies in the soil, providing up to 20 years of protection against Japanese beetle grubs. While it’s pricier than chemical alternatives (expect to pay $30–$50 per container), its longevity and environmental safety make it a favorite among organic gardeners. Shops often carry complementary products, like beneficial nematodes, to enhance soil health and pest resistance. This holistic approach sets them apart from retailers that prioritize quick fixes over sustainable results.
For those new to Milky Spore, specialty shops demystify the application process. They’ll explain that the spores must be applied to moist soil and watered in immediately to activate the bacteria. Reapplication every 4–6 weeks during the initial season ensures maximum soil penetration. Some shops even offer application tools, like spreaders or measuring spoons, to simplify the process. This hands-on support is invaluable, especially for first-time users who may feel overwhelmed by the technical details of biological pest control.
Comparing specialty shops to online retailers highlights their unique value. While Amazon or eBay may offer Milky Spore at competitive prices, they lack the personalized guidance that comes with in-person shopping. Specialty shops often host workshops or provide printed guides on integrated pest management, helping customers understand how Milky Spore fits into a broader strategy. Additionally, buying locally ensures product freshness, as Milky Spore’s viability can degrade if improperly stored or shipped. This local expertise and reliability make specialty shops the go-to choice for serious gardeners.
Finally, specialty pest control shops foster a community of informed consumers. Many host forums or social media groups where customers share success stories and tips, such as combining Milky Spore with aeration for better soil absorption. This collaborative environment encourages experimentation and learning, turning pest control from a chore into a shared passion. By choosing these shops, you’re not just buying a product—you’re joining a network of like-minded individuals committed to sustainable, effective solutions.
Spore Syringe Shelf Life: Room Temperature Storage Duration Explained
You may want to see also

Agricultural Supply Stores
One of the advantages of buying milky spore from agricultural supply stores is the opportunity to consult with knowledgeable staff. Unlike big-box retailers, these stores often employ experts who can provide tailored advice on application timing and dosage. For optimal results, apply milky spore in late summer or early fall when grubs are actively feeding. The recommended rate is 1 to 2 ounces per 1,000 square feet, mixed with water for even distribution. Staff may also suggest pairing milky spore with other organic treatments, such as beneficial nematodes, for enhanced pest control.
While agricultural supply stores offer expertise, they may not always be the most convenient option. Many are located in rural areas, requiring a dedicated trip for urban or suburban customers. However, this inconvenience is often offset by competitive pricing and the availability of commercial-grade products. For example, a 20-pound bag of milky spore might cost $150 at an agricultural store, compared to $200 for smaller quantities at specialty garden centers. If visiting in person is impractical, many stores now offer online ordering with curbside pickup or delivery, bridging the accessibility gap.
A lesser-known benefit of shopping at agricultural supply stores is access to complementary tools and equipment. Applying milky spore effectively often requires a spreader or sprayer, both of which are readily available at these stores. For instance, a broadcast spreader ensures even distribution of the granular product, while a hose-end sprayer can be used for liquid formulations. Some stores even offer rental equipment for one-time users, reducing the upfront investment. By bundling purchases, customers can save time and ensure they have everything needed for successful application.
Finally, agricultural supply stores often serve as hubs for local agricultural communities, providing additional resources beyond products. Many host workshops or seminars on topics like integrated pest management, where milky spore is frequently discussed. These events offer hands-on learning and networking opportunities, allowing customers to share experiences and tips. For example, a workshop might demonstrate how to test soil moisture before application, as milky spore requires damp conditions to activate. By leveraging these resources, buyers can maximize the effectiveness of their milky spore investment and contribute to a healthier, more sustainable landscape.
Mastering Mushroom Cultivation: A Step-by-Step Guide to Using Spore Syringes
You may want to see also
Frequently asked questions
Milky spore can be purchased at most garden centers, home improvement stores like Home Depot or Lowe's, and online retailers such as Amazon or specialized gardening websites.
Yes, many local nurseries and garden supply stores carry milky spore, especially those focused on organic or eco-friendly lawn care products.
Yes, milky spore is often available in bulk quantities from agricultural supply stores, online retailers, or directly from manufacturers for treating larger lawn areas.